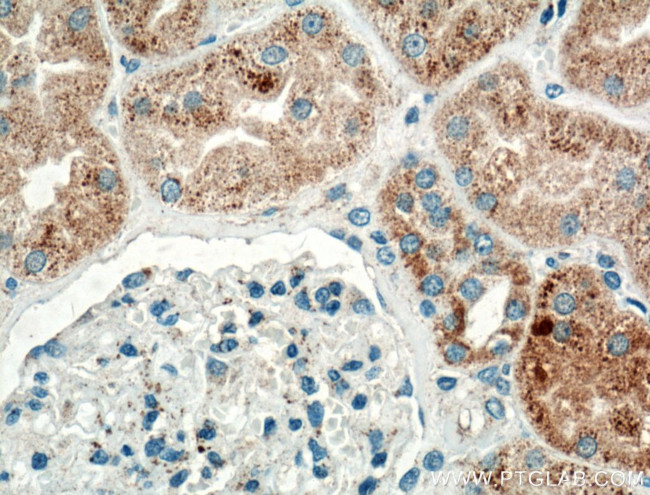
TIMP-2 Antibody in Immunohistochemistry (Paraffin) (IHC (P))
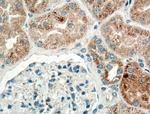
TIMP-2 Antibody in Immunohistochemistry (Paraffin) (IHC (P))

Search
Proteintech
TIMP-2 Polyclonal Antibody
{{$productOrderCtrl.translations['antibody.pdp.commerceCard.promotion.promotions']}}
{{$productOrderCtrl.translations['antibody.pdp.commerceCard.promotion.viewpromo']}}
{{$productOrderCtrl.translations['antibody.pdp.commerceCard.promotion.promocode']}}: {{promo.promoCode}} {{promo.promoTitle}} {{promo.promoDescription}}. {{$productOrderCtrl.translations['antibody.pdp.commerceCard.promotion.learnmore']}}
产品信息
17353-1-AP
种属反应
已发表种属
宿主/亚型
分类
类型
抗原
偶联物
形式
浓度
规格
纯化类型
保存液
内含物
保存条件
运输条件
产品详细信息
Immunogen sequence: RTLRLALGL LLLATLLRPA DACSCSPVHP QQAFCNADVV IRAKAVSEKE VDSGNDIYGN PIKRIQYEIK QIKMFKGPEK DIEFIYTAPS SAVCGVSLDV GGKKEYLIAG KAEGDGKMHI TLCDFIVPWD TLSTTQKKSL NHRYQMGCEC KITRCPMIPC YISSPDECLW MDWVTEKNIN GHQAKFFACI KRSDGSCAWY RGAAPPKQEF LDIEDP (6-220 aa encoded by B C052605)
靶标信息
TIMP-1 and TIMP-2 are inhibitory enzymes of matrix metalloproteinase family, and are thought to be of great importance in the maintenance of connective tissue integrity. TIMP-2 shows the highest binding affinity to both the latent (pro) and active forms of 72 kDa Type IV collagenase (also known as MMP-2 or gelatinase A). It also has affinity for the active form of 92 kDa Type IV collagenase (also known as MMP-9 or gelatinase B). TIMP-2 inhibits the proteolytic invasiveness of tumor cells and normal placental trophoblast cells.
仅用于科研。不用于诊断过程。未经明确授权不得转售。
生物信息学
蛋白别名: CSC-21K; Metalloproteinase inhibitor 2; metalloproteinase inhibitor precursor; metalloproteinase-2 inhibitor precursor; testicular secretory protein Li 57; TIMP 2; TIMP-2; tissue inhibitor of metalloproteinase 2; Tissue inhibitor of metalloproteinases 2; unnamed protein product
基因别名: CSC-21K; D11Bwg1104e; DDC8; Timp-2; TIMP2
UniProt ID: (Human) P16035, (Rat) P30121
Entrez Gene ID: (Human) 7077, (Rat) 29543, (Mouse) 21858